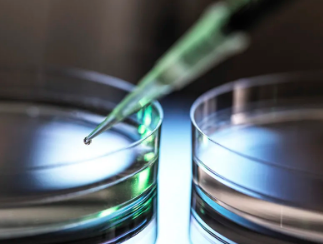
image.png

干細胞治療倫理問題有哪些?解決問題思路
2024-11-08 14:43:51 來源: 小編 咨詢醫(yī)生
干細胞治療作為一種前沿的生物技術,已經(jīng)在很多疾病領域展現(xiàn)出巨大的潛力。然而,隨著干細胞治療技術的不斷發(fā)展,一系列倫理問題也日益凸顯。以下是干細胞治療倫理問題的概述及解決思路。
一、倫理問題
1.干細胞來源問題
干細胞的來源包括胚胎干細胞、成體干細胞和誘導多能干細胞。其中,胚胎干細胞來源的倫理爭議最大,因為其涉及到胚胎的破壞。此外,成體干細胞和誘導多能干細胞的獲取也可能涉及**權益和隱私保護等問題。
2.治療效果與風險
干細胞治療的效果尚不明確,存在一定的不確定性。在治療過程中,患者可能會面臨風險,如免疫排斥、腫瘤形成等。如何平衡治療效果與風險,是倫理層面需要關注的問題。
3.社會公平與資源分配
干細胞治療技術的高昂成本使得很多患者難以承擔。如何保證社會公平,合理分配醫(yī)療資源,使更多患者受益,是倫理層面的重要議題。
4.科研倫理
在干細胞治療研究中,可能存在數(shù)據(jù)造假、篡改實驗結果等科研不端行為。這些行為不僅損害了科研的公正性,還可能導致患者利益受損。
二、解決問題思路
1.完善法律法規(guī)
建立健全干細胞治療相關法律法規(guī),明確干細胞來源、使用、監(jiān)管等方面的規(guī)定,確保干細胞治療在法律框架下進行。
2.嚴格審查與監(jiān)管
對干細胞治療項目進行嚴格審查,確保研究合規(guī)、安全。同時,加強對干細胞治療機構的監(jiān)管,防止非法行醫(yī)和濫用技術。
3.增加科研投入
加大干細胞治療領域的科研投入,推動技術進步,提高治療效果,降低治療成本,使更多患者受益。
4.倡導公益性質
鼓勵醫(yī)療機構開展公益性質的服務,如設立干細胞治療基金,為貧困患者提供援助,降低患者的經(jīng)濟負擔。
5.加強倫理教育
對從事干細胞治療研究的科研人員、醫(yī)護人員進行倫理教育,提高其倫理素養(yǎng),防止科研不端行為。
總之,干細胞治療倫理問題的解決需要多方面的努力,包括法律法規(guī)的完善、科研投入的增加、倫理教育的加強等。只有在保證倫理原則的前提下,干細胞治療技術才能更好地造福人類。
-
上一頁: 治耳鳴的干細胞療法有效果嗎?效果如何?
- 2024-10-24干細胞治療腦梗死效果及優(yōu)勢如何?如何評估其成功率?
- 2024-10-24干細胞治療脊柱修復效果如何?如何選擇最佳干細胞治療脊柱方案?
- 2024-11-10干細胞治療脊柱炎可以根治嗎,效果如何
- 2024-11-16目前進入臨床的干細胞療法有哪些,其效果對比如何
- 2024-10-14干細胞療法有什么作用?干細胞療法作用機理研究進展如何?
- 2024-09-03紫草干細胞的作用與用途是什么
- 2024-08-06存儲干細胞費用,存儲干細胞有什么用
- 2024-08-10干細胞抗衰危險嗎能維持多久
- 2024-08-29干細胞治療肝硬化費用明細詳解
- 2024-07-18干細胞移植治療帕金森的費用大概多少,干細胞治療帕金森的效果費用介紹
- 2024-08-06干細胞去哪里打比較正規(guī),打干細胞的好處和壞處
- 2024-09-27貴州醫(yī)院干細胞治療可靠嗎?如何選擇醫(yī)院和專業(yè)?
- 2024-10-11上海干細胞醫(yī)療中心有幾家?如何選擇專業(yè)機構?
- 2024-07-24干細胞治療肝硬化,干細胞治療肝硬化效果怎么樣
- 2024-10-11牙髓干細胞研究進展如何?臨床應用效果怎樣?
- 2024-09-14遼寧推薦干細胞檢測機構,這幾家很靠譜
- 2024-09-23干細胞如何注射效果好,干細胞注射的作用與功效
- 2024-09-13陜西臍帶干細胞存儲費用高嗎,是不是智商稅
